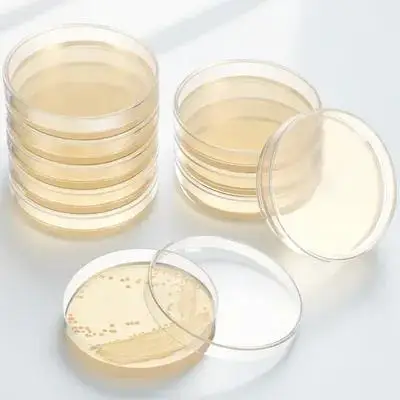

Суперпрочная нейлоновая рыболовная леска KENARDO, 5 шт., многонитевая прозрачная рыболовная леска, рыболовные лески
График изменения цены & курс обмена валют
Пользователи также просматривали

$41.23
Dual drive 48V 350W BLDC Electric scooter controller E-bike 2 pcs brushless speed driver one set
aliexpress.com
$2.29
Car Cleaning Glove For Mitsubishi GT-PHEV XR-PHEV Delica Xpander L200 Mirage Samurai EX Attrage FORTIS
aliexpress.com
$22.50
Mini LED cabinet light 3w 5W COB mini LED downlight AC85V-265V Mini spot lamp white or Warm white RoHS CE with led driver
aliexpress.com
$22.65
Mug Hooks Wall-Mounted Holder,Coffee Cups Holder Hanger No Drilling,Mug Rack Hooks With 4 Cup Holders,For Kitchen Office
aliexpress.com
$12.26
Оперативная Память DDR4 4 Гб 2666 МГц, ОЗУ для настольного компьютера, 1,2 в, DIMM 288Pin
aliexpress.com
$84.49
Pixie Cut Wig T Part Lace Bob Human Hair Water Wave Short Lace Wig Colored Curly Bob Remy Wigs Brazilian Side Part Pre Plucked
aliexpress.com
$37.49
Sea frogs Aluminium Diving Handle for Underwater Camera for Canon Sony DSLR Diving Case Tripod Handle Diving Equipment
aliexpress.com
$59.90
African Beads Jewelry Set Crystal Beads style Necklace Set women nigerian wedding bridal necklace jewelry set W6008
aliexpress.com
$15.53
Экономия места поворотный держатель для полотенец не пробивая настенный держатель для полотенец туалетная штанга для полотенец ванная комната
joom.ru
$51.55
A36E 4G Network WiFi GPS SOS Smart Watch Kids Video Video Alarm Alarch Came Camer - Bleu
tvc-mall.com
$2.83
Carbon Fiber Comb Lady Long Hair Pointed Tail Comb Household Hairdressing Haircut Household Hair Styling Comb
aliexpress.com
$11.86
Женская толстовка с капюшоном и надписью Love, Женская флисовая Толстовка свободного покроя с длинным рукавом и круглым вырезом, зимние пулов...
aliexpress.com
$12.68
Car Windshield Protection Cover Auto Multifunction Snow Ice Frost Dust Sun Shade Guard Car Outdoor Windscreen Protector
aliexpress.com
$13.00
Arrival Women Retro Jeans Shorts Summer High Waisted Rolled Denim Jean Shorts with Pockets
aliexpress.com
$7.60
Kids Slippers New Boy Cartoon Panda Slippers Children Soft Bottom Anti-skid Slippers Boys Girls Home Shoes Toddler Slippers
aliexpress.com
$7.99
Children's Pure Cotton Socks Girl And Boy Casual Sock Middle Tube Cartoon Spring Autumn Outdoor Cute Sport Hose Baby Accessories
aliexpress.com
$13.44
Mesh Flats Fashion Shoes Woman Men Casual Shoes Large Sizes Couple Lightweight Breathable Slip-on Chaussure Homme Male Female
aliexpress.com
$11.49
M&G Hexagon Pre-sharpened HB School Pencils with Eraser Lead Wood Pencil Wooden Graphite Pencil Stationery School
aliexpress.com
$4.27
Large Piano Tuning Tool Kit 120pcs Black Storage Bag Portable Reusable ganizer for Instruments Accessories Tools Oxford
aliexpress.com
$12.53
New Creative Car Whiskey Bottles Car Model Wine Bottle Glass Bottle Transparent Decanter Home Decor Gift for Whiskey Enthusiasts
aliexpress.com
$1.74
30pcs Phone Phone Suction Cups Computer Removal Repair Tool Set Durable Practical Suction Cups For Screen Gift
aliexpress.com
$2.16
Bed Edge Hooks 7 Letters Connector Iron Plastic Coated Bunk Bed Ladder Accessories 18mm White Heavy Duty Storage Solution
aliexpress.com
$3.62
Thimble Finger Protector Embroidery Guard Knitting Needlework Supplies Sewing Protectors Durable Soft Sheepskin DIY
aliexpress.com
$15.61
4 Pcs Blank Cylinder Blank Cylinder DIY Paper Roll Tubes Craft Projects Refillable Kids Storage Brown Paper Roll
aliexpress.com
$11.89
20 Pcs Outdoor Nutrient Agar Plate Travel Plates for Science Experiment Petri Dishes
aliexpress.com
$3.42
Rhythm Sand Ball Musical Instrument Kids Percussion Shaker Educational Plaything Hand-Eye Coordination Finger Shaking Ball
aliexpress.com
$3.07
Retro Branch Handle Cupboard Door Knob Zinc Alloy Drawer Knobs for Cabinets Drawers Removable Handles
aliexpress.com
$0.96
1pc Tissue Box Holder Compact Paper Towel Box Size Home Bathroom Car Multi-purpose Dispenser Multi-Purpose Tissue Holder Storage
aliexpress.com
$1.03
4pcs Cotton Swab Container Portable Travel Dispenser Transparent Case Bathroom Storage Jars Small HOLDER For Swabs Toothpicks
aliexpress.com
$6.30
YouLaPan Wedding Pearl Hair Comb Bride Rhinestone Headpiece Women Hairwear Bridal Hair Accessories Women Fashion Headwear HP797
aliexpress.com
$4.91
Subtle Oriental Keychain Labubu Outfit Fairy Princess Dress with Shoes for 1st-3rd Gen Traditional Costume
aliexpress.com
$135.10
Original New DQ400 0DD Transmission Valve Plates with Hole 0DD325065E For Audi VW Seat DQ400E Auto Parts
aliexpress.com
$18.37
Sumitomo FC-6S fiber cleaver fixture FC-6S domestic imported 4 in 1 Crimping Slot Pressing Board 0.2mm, 0.9mm, 3mm
aliexpress.com
$29.24
Age Reduction JK Girl Summer New Short Sleeve White Turn-down Collar Shirt Simple Slim Versatile Age Reduction Solid Color Top
aliexpress.com
$3.69
280 Pcs Mini Fake Wall Bricks Decorative Brick Models for Model Train Layout School Project Sand Table Landscaping Kids Room
aliexpress.com